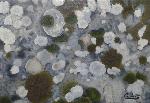

EXPOSICIONES - ARTE EN LA T2
AENA T2 aeropuerto de Madrid
Exposiciû°n junto a artistas de Madrid AcademûÙa de Arte.
Ver noticias sobre la exposiciû°n.
OBRAS EXPOSICIûN ARTE EN LA T2

Puerto fluvial de Europa septentrional (Rafael DûÙaz Maderuelo)

Inauguraciû°n de exposiciû°n en Kubo Kutxa, Donostia (Rafael DûÙaz Maderuelo)

La Mancha vista por Turner (Rafael DûÙaz Maderuelo)

Edificio EspaûÝa en 2017 (Rafael DûÙaz Maderuelo)

Nadadores melanesios (Rafael DûÙaz Maderuelo)

Playa de Agualique en Fuenteventura (Rafael DûÙaz Maderuelo)

Sombras (NicolûÀs del Real)

CûÀlida sombra del arce (NicolûÀs del Real)

Patio interior (NicolûÀs del Real)

La maceta (NicolûÀs del Real)

Plaza de Legazpi (NicolûÀs del Real)

Regato (Ana E. SûÀnchez)

Carretera de DoûÝana a Huelva (Ana E. SûÀnchez)

Abedules (Ana E. SûÀnchez)

Oporto (Ana E. SûÀnchez)

Fachada cubana (Elena Marchini)

OtoûÝo (Elena Marchini)

Carlo (Elena Marchini)

Descanso (Elena Marchini)

Enzo (Elena Marchini)

Sensualidad (Elena Marchini)

Actitudes (ûngel de Domingo)

Padre (ûngel de Domingo)

Mochuelo (Concha Senderuela)

Alas de mariposa (Concha Senderuela)

Naranjas y limones (Concha Senderuela)
Roca (Concha Senderuela)

Reflejos de El Capricho (Concha Senderuela)

Wisteria (Concha Senderuela)

La ola (Concha Senderuela)

Ventana con macetas (VûÙctor Calvo)

Chapuzû°n trûÀgico (VûÙctor Calvo)

Escapada (VûÙctor Calvo)

Atardecer en Peguerinos (VûÙctor Calvo)

Acarreando uva (copia) (VûÙctor Calvo)

El Retiro I (VûÙctor Calvo)

El Retiro II (VûÙctor Calvo)

El Retiro III (VûÙctor Calvo)

Nubes de atardecer (Drusila Dones)

Nubes de tormenta (Drusila Dones)

Campos de Castilla (Carolina Romero)

Campamento (Carolina Romero)

Puente de Segovia (Maite Ramos)

Carrera de San Jerû°nimo (ûngelô ûlvarez Corona)

Irene (Salvador Antû¤nez)

Paseo nocturno (Isabel ûvila)

Atardecer en Ayamonte (Marcos Chica)

Piedad en Palestina (Ana Isabel GonzûÀlez Lû°pez)

'la Torre del Clavero' Salamanca (Fernando MarûÙn)

Concha (Concepciû°n del Mazo)

Mamen (Irene Municio)

Grandeza / greatness (Mani Padial)

Salvador (Natalia Solûˋ)


